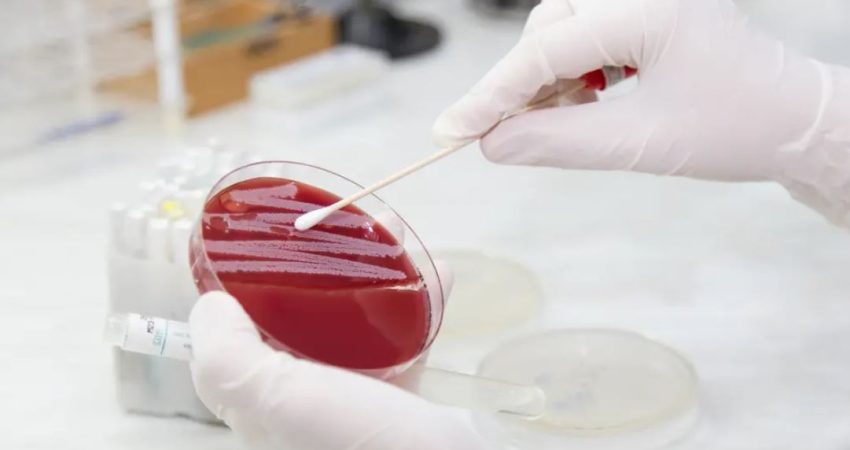

Miliona jetë mund të shpëtohen me një antibiotik që mund të trajtojë superbakteret rezistente ndaj ilaçeve, pas një zbulimi nga shkencëtarët në Mbretërinë e Bashkuar. Studiuesit thanë se kishin zhvilluar versione të reja të një molekule që mendohet se është e aftë të vrasë bakteret pa dëmtuar indin e gjitarëve.
Teixobactin u zbulua në vitin 2015 , por projekti i ri ka zhvilluar klasa “sintetike” të antibiotikut që mund të shkatërrojë një gamë të gjerë mikrobesh të marra nga pacientët njerëzorë, thanë shkencëtarët.
Ata gjithashtu zhdukën me sukses Staphylococcus aureus rezistent ndaj meticilinës (MRSA), i cili është rezistent ndaj disa antibiotikëve të përdorur gjerësisht, në një studim mbi minjtë.
Studiuesi kryesor Ishwar Singh i Universitetit të Liverpool-it tha se zbulimi ishte një hap i rëndësishëm drejt zhbllokimit të potencialit të plotë mjekësor të teixobactin për të trajtuar rezistencën antimikrobike (AMR).
“Qëllimi ynë përfundimtar është që të kemi një numër të barnave të qëndrueshme nga platforma jonë sintetike modulare teixobactin, e cila mund të përdoret si një ‘vijë e fundit e mbrojtjes’ kundër superbaktereve për të shpëtuar jetët e humbura aktualisht për shkak të rezistencës ndaj antibiotikëve,” tha ai.
Më shumë se 1.2 milionë njerëz vdiqën nga infeksionet bakteriale rezistente ndaj antibiotikëve në vitin 2019, pasi u bënë shkaku kryesor i vdekjeve në mbarë botën, sipas një studimi të botuar në “The Lancet” në janar.
Covid-19 mendohet gjithashtu se po përshpejton kërcënimin global të rezistencës ndaj antibiotikëve. Pacientët mund të trajtohen me vetëm një dozë teixobactine në ditë për infeksione bakteriale sistemike rezistente kërcënuese për jetën, tregojnë testet.
Versionet sintetike mund të mbahen gjithashtu në temperaturën e dhomës, duke e bërë më të lehtë shpërndarjen globale duke hequr nevojën për zinxhirë të ftohtë dhe ato mund të prodhohen me çmim të ulët në një shkallë të madhe, thanë studiuesit.
Burimi: The Independent/ Përshtati: Gazeta “Si”
Copyright © Gazeta “Si”
Të gjitha të drejtat e këtij materiali janë pronë ekskluzive dhe e patjetërsueshme e Gazetës “Si”, sipas Ligjit Nr.35/2016 “Për të drejtat e autorit dhe të drejtat e tjera të lidhura me to”. Ndalohet kategorikisht kopjimi, publikimi, shpërndarja, tjetërsimi etj, pa autorizimin e Gazetës “Si”, në të kundërt çdo shkelës do mbajë përgjegjësi sipas nenit 179 të Ligjit 35/2016.
.png)